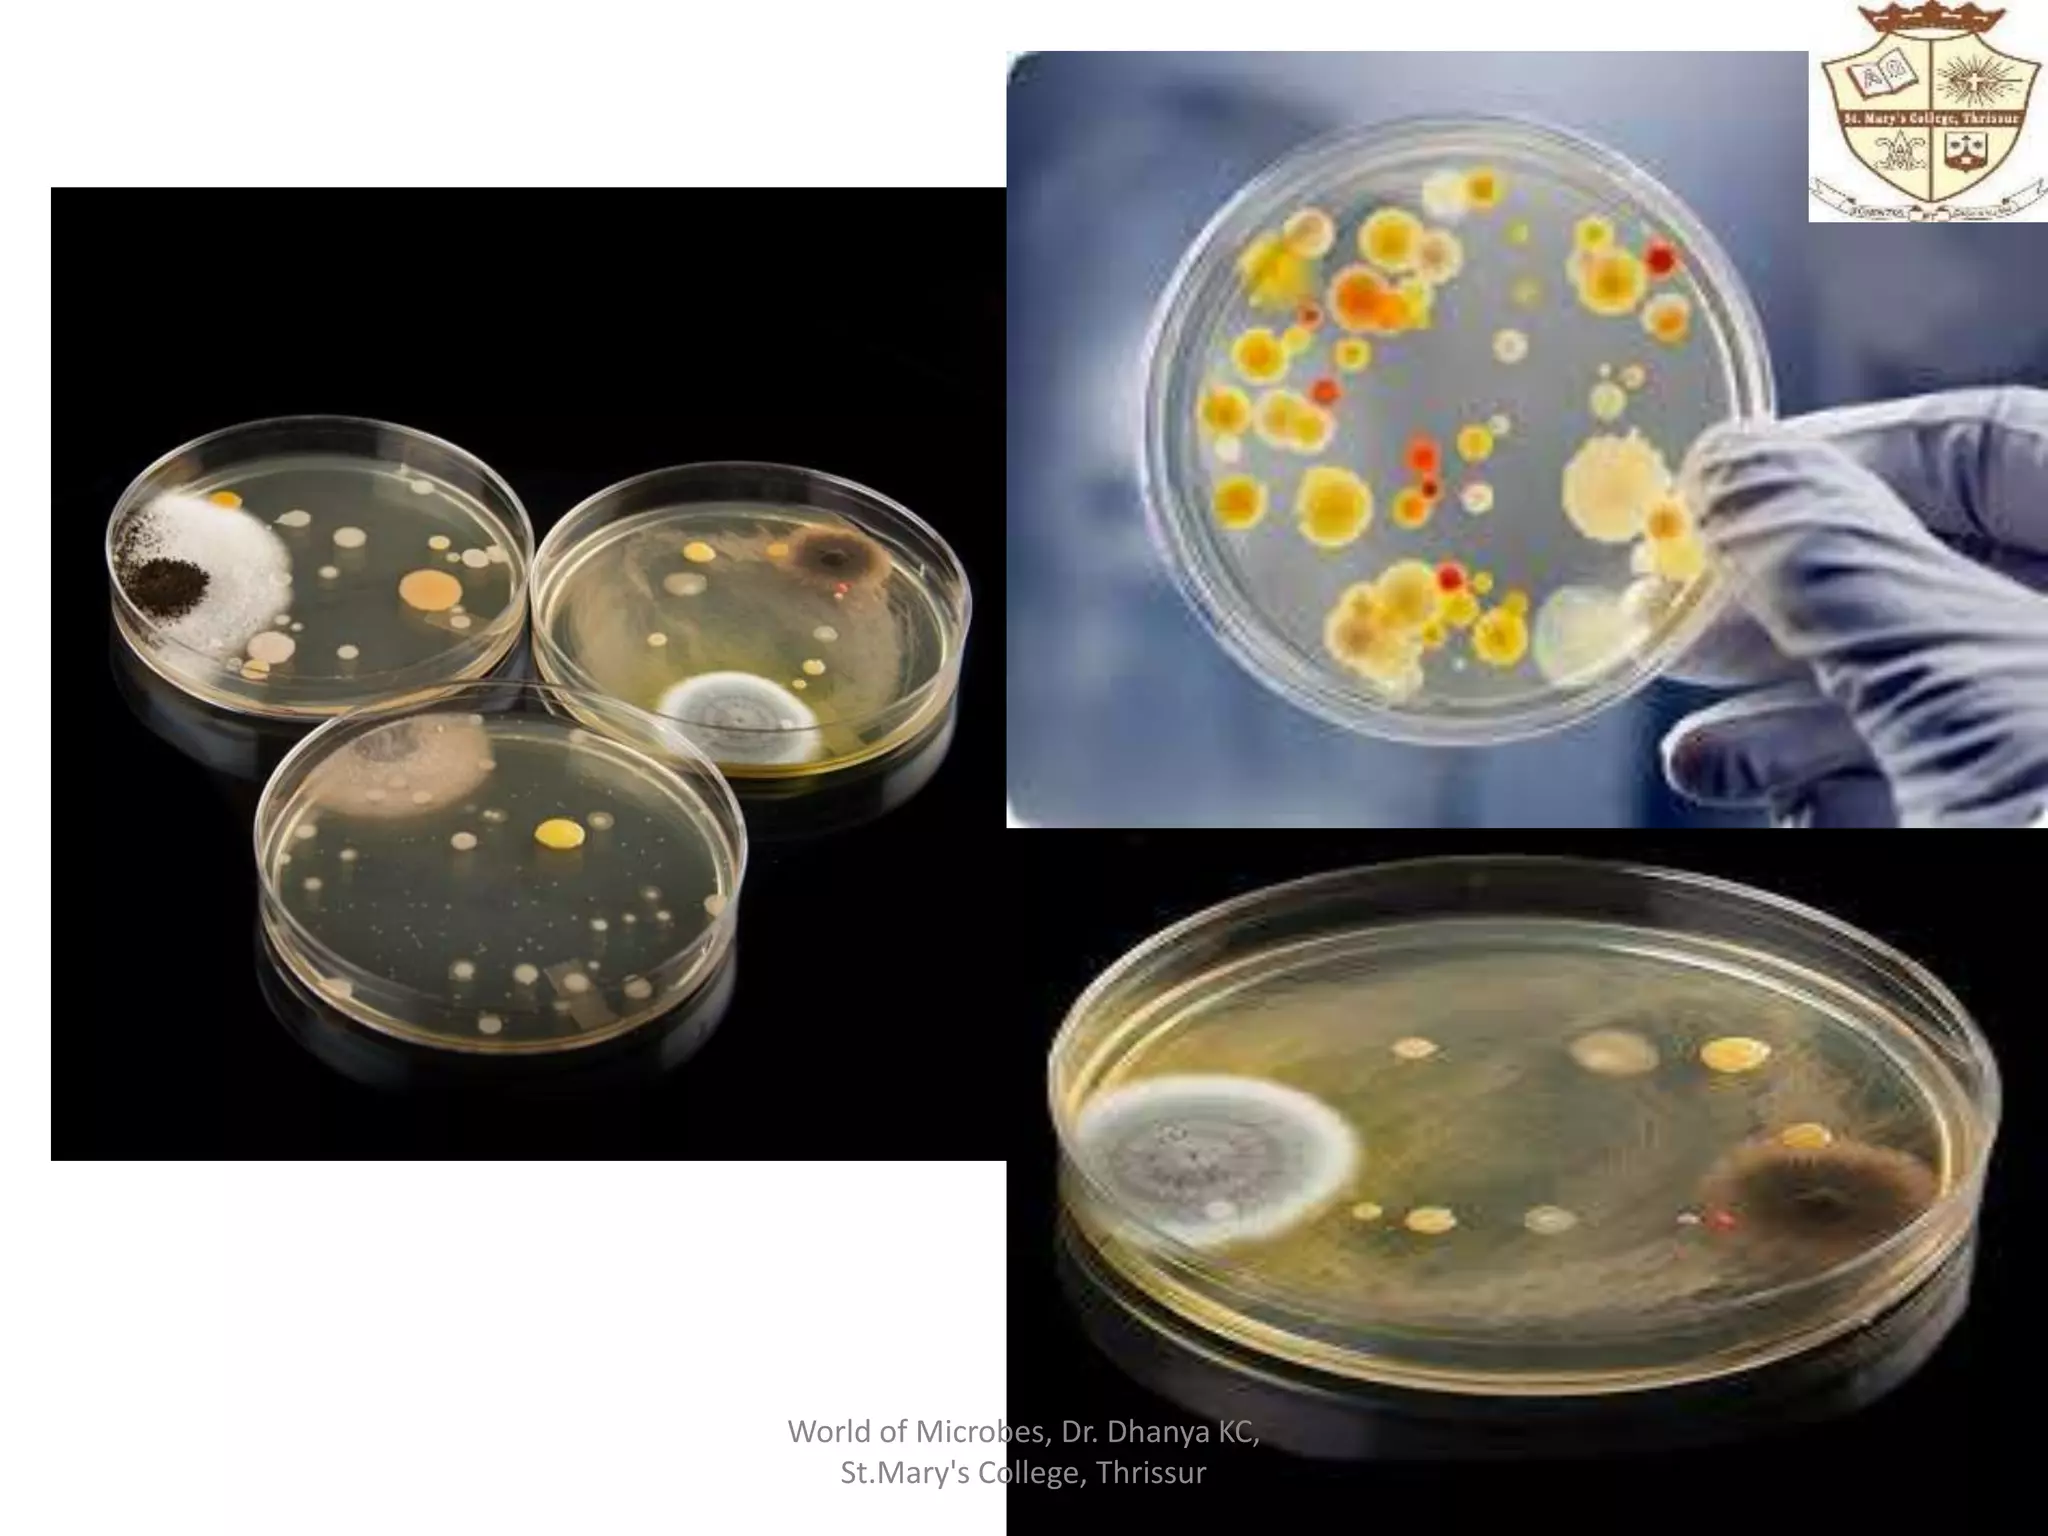
World of Microbes, Dr. Dhanya KC,
St.Mary's College, Thrissur

The document discusses microbiology and the world of microbes. It describes microbiology as the study of microorganisms that can only be seen with a microscope, including viruses, bacteria, protozoa, fungi, and algae. It notes that microbes are omnipresent in all environments and have significant impacts on humans, though most do not cause disease. The document also discusses the human microbiome and our symbiotic relationship with microbes, as well as emerging issues like antibiotic resistance and potential applications of microbes in fields like biotechnology and environmental remediation.